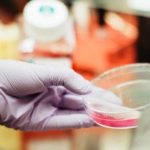

Μια χούφτα καρύδια κάθε μέρα μπορεί να… μειώσει τους παράγοντες κινδύνου για τον διαβήτη τύπου 2, σύμφωνα με μια νέα μελέτη, η οποία δημοσιεύθηκε στην επιστημονική επιθεώρηση BMJ Open Diabetes Research & Care…
Οι συμμετέχοντες στη μελέτη έτρωγαν λίγα καρύδια κάθε μέρα για έξι μήνες και είδαν βελτιώσεις στην λειτουργία των αιμοφόρων αγγείων τους και μειώσεις στα επίπεδα της «κακής» (LDL) χοληστερόλης στο αίμα τους, σε σύγκριση με εκείνους που δεν κατανάλωναν καρύδια.
Η κακή λειτουργία των αιμοφόρων αγγείων και τα υψηλά επίπεδα της LDL χοληστερόλης είναι παράγοντες κινδύνου για διαβήτη τύπου 2.
Τα καρύδια είναι πλούσια σε απαραίτητα λιπαρά οξέα και άλλα θρεπτικά συστατικά, όπως το φυλλικό οξύ και η βιταμίνη Ε. Ωστόσο, έχουν, επίσης, αρκετά υψηλή περιεκτικότητα σε θερμίδες, είπε ο δρ David Katz, επικεφαλής συγγραφέας της μελέτης και ιδρυτικό μέλος και διευθυντής του Ερευνητικού Κέντρου Πρόληψης Yale-Griffin στο Κονέκτικατ των ΗΠΑ.
Οι ερευνητές αξιολόγησαν την υγεία των συμμετεχόντων με πολλούς τρόπους, συμπεριλαμβανομένης της μέτρησης του ύψους, του βάρους, του Δείκτη Μάζας Σώματος (ΔΜΣ), της συνολικής ποιότητας της διατροφής τους, της περιμέτρου της μέσης τους, της αρτηριακής τους πίεσης, των επιπέδων χοληστερόλης και γλυκόζης και της λειτουργίας των αιμοφόρων αγγείων (η οποία μετριέται με υπερηχογραφικό έλεγχο).
Μετά λαμβάνοντας υπόψη παράγοντες όπως η ηλικία των συμμετεχόντων, τα επίπεδα άσκησης και τη λήψη θερμίδων και λιπαρών οξέων, οι ερευνητές διαπίστωσαν ότι όταν οι συμμετέχοντες έτρωγαν καρύδια, η λειτουργία των αιμοφόρων αγγείων τους βελτιώθηκε και το ίδιο συνέβη και στην συνολική ποιότητα της διατροφής τους, ανεξαρτήτως του τύπου του διαιτητικού προγράμματος που ακολουθούσαν.
Επιπροσθέτως, η προσθήκη καρυδιών στην καθημερινή τους διατροφή δεν είχε καμία επίδραση στην αρτηριακή πίεση ή τα επίπεδα της «καλής» (HDL) χοληστερόλης, ενώ τα επίπεδα της γλυκόζης στο αίμα των συμμετεχόντων έδειξαν αυξητικές τάσεις κατά τη διάρκεια της μελέτης, ανεξάρτητα από το διατροφικό πρόγραμμα που ακολουθούσαν.
Ωστόσο, η περίμετρος της μέσης των συμμετεχόντων που έτρωγαν μια χούφτα καρύδια κάθε μέρα μειώθηκε σημαντικά όταν η διατροφή με καρύδια συνδυάστηκε με την παροχή συμβουλών για τον περιορισμό των θερμίδων.
Πηγή: iatropedia